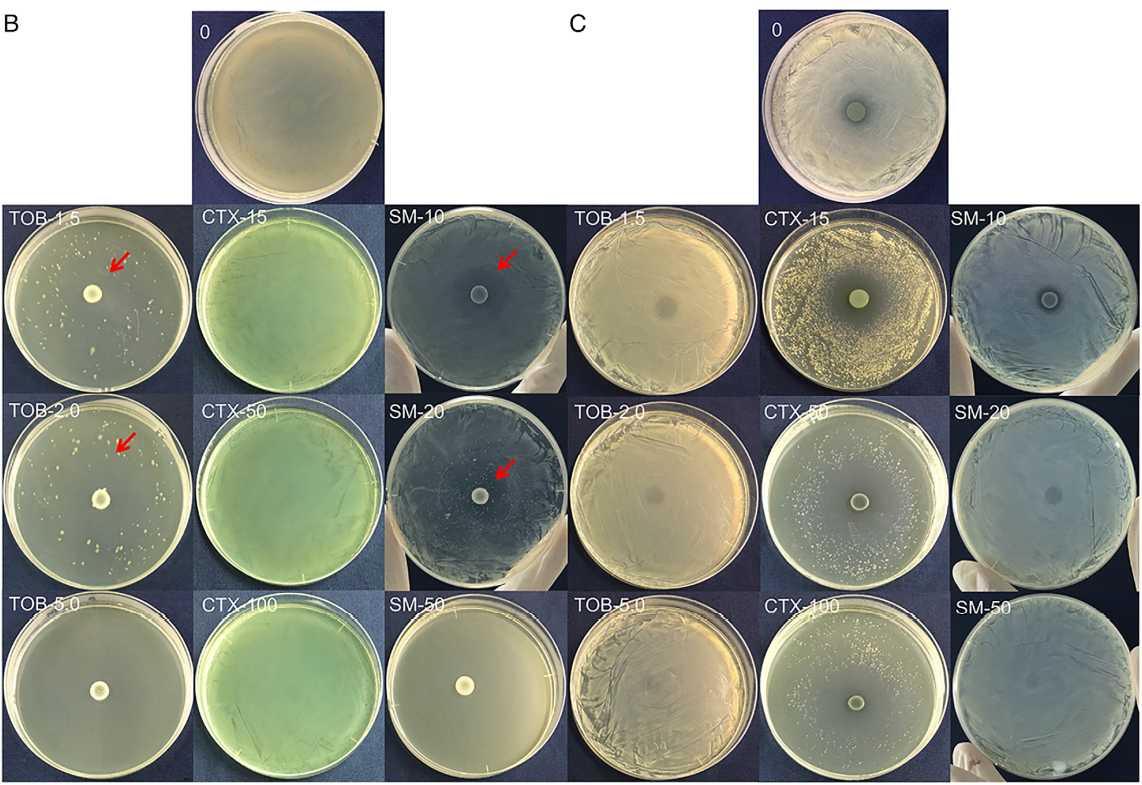
急思广益|抗生素干预影响铜绿假单胞菌和mrsa间的动态相互作用

铜绿假单胞菌平板图片

橡皮糖你吃过,橡皮一样的铜绿你见过吗?
图片尺寸887x926
【微生物检测】 gb19298桶装水中铜绿假单胞菌的生化检测
图片尺寸480x238
医学检验辅导:铜绿假单胞菌
图片尺寸500x375
铜绿假单胞菌简介
图片尺寸310x232cn平板(9cm) 用于铜绿假单胞菌的分离培养 欧克生物
图片尺寸750x490
铜绿假单胞菌,粘液性铜绿假单胞菌的药敏选择
图片尺寸854x783
铜绿假单胞菌在cn琼脂平板上为蓝绿色菌落,如下图所示:在培养20h~24h
图片尺寸400x402
克氏琼脂平板(9cm) 用于铜绿假单胞菌的克氏试验 芜湖欧克
图片尺寸800x800
【微生物检测】 gb19298桶装水中铜绿假单胞菌的生化检测
图片尺寸1440x1080
急思广益|抗生素干预影响铜绿假单胞菌和mrsa间的动态相互作用
图片尺寸1142x785
七彩山鸡养殖场铜绿假单胞菌的耐药性多位点序列分型及遗传进化分析
图片尺寸1575x1276
铜绿假单胞菌
图片尺寸760x742
追踪痰中最常见的杀手之一铜绿假单胞菌
图片尺寸704x529
上述标本,细菌鉴定结果为铜绿假单胞菌,gram染色在显微镜(×1000)下
图片尺寸600x450
铜绿假单胞菌
图片尺寸366x211
铜绿假单胞菌
图片尺寸367x220
求助铜绿假单胞菌图谱
图片尺寸2048x1360
cn琼脂平板上铜绿假单胞菌和荧光假单胞菌的生长特征
图片尺寸1080x390
铜绿假单胞菌(绿脓杆菌)-北纳生物
图片尺寸417x417
饮用水中铜绿假单胞菌的污染,控制及检验_菌落_试验_进行
图片尺寸900x450
猜你喜欢:铜绿假单胞菌镜检图片铜绿假单胞菌菌落铜绿假单胞菌镜下铜绿假单胞菌镜下图片铜绿假单胞菌菌落形态铜绿假单胞菌血平板铜绿假单胞菌菌落图片铜绿假单胞菌图片铜绿假单胞菌形态图片铜绿假单胞菌菌落颜色铜绿假单胞菌铜绿假单胞菌形态铜绿假单胞菌培养基铜绿假单胞菌感染铜绿假单胞菌显微镜铜绿假单胞菌鞭毛铜绿假单胞菌感染表现铜绿假单胞菌伤口铜绿假单胞菌革兰染色铜绿假单胞菌痰液颜色铜绿假单胞菌生物膜椰毒假单胞菌图片假单胞菌沼泽红假单胞菌荚膜组织胞浆菌图片荧光假单胞菌椰毒假单胞菌恶臭假单胞菌铜绿菌假单胞菌属蓝天白云油菜花图片烧烤腌肉图片特区精神 内涵好看的小板凳图片娘山108星少女星将表再一次爱你红袖简谱大油豆腐膳魔师水壶盖拆装图解女士标准眉型图片我国的天然磨刀石提醒自己要忍的壁纸2020最火手机壁纸抖音